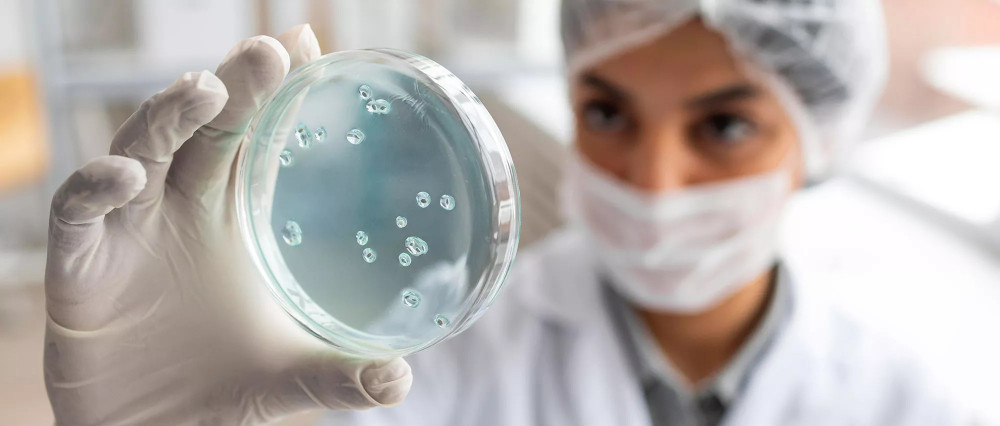

شامبو للشعر الضعيف يعيد القوة والحيوية لشعرك
إذا ذا كنت تعاني من الشعر الضعيف وتبحث عن الحل المثالي، فإن شامبو للشعر الضعيف من نوجيلا هو الخيار الأمثل لك

إذا ذا كنت تعاني من الشعر الضعيف وتبحث عن الحل المثالي، فإن شامبو للشعر الضعيف من نوجيلا هو الخيار الأمثل لك

احصلي على شعر أحلامك مع فرشاة تنشيط الشعر المصممة لتغذية فروة الرأس وتعزيز صحة شعرك. تقنية مبتكرة تمنحك نتائج مذهلة في و...

ودّعي التلف الناتج عن المناشف التقليدية مع منشفة بالينيز للف الشعر! بتصميمها العملي والمبتكر

دللي شعرك مع بخاخ عناية بالشعر المصمم ليكون الحل المثالي لكافة مشاكلك! بفضل تركيبته المغذية

هل شعرك يعاني من التساقط؟ الحل بين يديك الآن! شامبو علاج تساقط الشعر يمنحك نتائج مضمونة بفضل تركيبته الغنية بالمكونات ال...

اكتشف فوائد استخدام أفضل بلسم ضد تساقط الشعر الذي يعزز قوة الشعر ويمنع تقصفه

استعيدي قوة ولمعان شعرك مع امبولات الكيراتين للعناية بالشعر من نوجيلا آند سولي بتركيبة غنية بالبروتينات المغذية

امنحي شعرك العناية التي يستحقها مع امبولات اصلاح الشعر الحل المثالي للشعر التالف والجاف

احصلي على شعر صحي وقوي مع امبولات لشعر حيوي الحل المثالي لتغذية الشعر من الجذور وحتى الأطراف

تخلصي من مشكلة تساقط الشعر بسهولة مع أفضل امبولات لعلاج تساقط الشعر تركيبة مبتكرة تعمل على تغذية فروة الرأس وتقوية جذور...

مستخلص البصل الأحمر

الجليكوجين البحري
بيو-كابيجن بي تي

مستخلص الكينوا

الأنديز ماكا